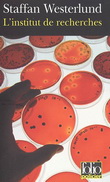

X Fermer
![]()
|
|

|
$15.95
Depuis plusieurs années, Sibylla vit dans l'ombre, fuyant le souvenir de son enfance, en marge de la société dans laquelle elle ne se reconnaît pas.
Mais elle est soudain projetée sur le devant de... » Read more...
SEUIL
|
November 2005
|
Upon order :
2 to 4 weeks
|
|
|
|
|

|
$34.95
« Åke Edwardson, le Simenon du froid. » . En cette fin d'été, il fait une chaleur inhabituelle à Göteborg. Le cadavre d'une jeune femme est retrouvé dans l'un des parcs de la ville. Ce m... » Read more...
LATTES
|
October 2005
|
Out of stock :
Unavailable
|
|
|
|
|

|
$39.95
Fin août 2001, dans la forêt aux abords d'Ystad, la police fait une atroce découverte: une tête de femme coupée, deux mains jointes comme pour la prière reposent près d'une bible aux pages g... » Read more...
SEUIL
|
October 2005
|
Upon order :
2 to 4 weeks
|
|
|
|
|

|
$17.95
Qui sont les monstres ?... Quelque part au Brésil, un homme meurt d'une balle dans la tête. En Suède, une fillette qui aimait les oiseaux disparaît sans motif apparent et sans laisser la moin... » Read more...
GALLIMARD
|
May 2005
|
Upon order :
2 to 4 weeks
|
|
|
|
|

|
$18.95
La Belle dormit cent ans
Une enquête de Varg Veum, le privé norvégien. Traduit du norvégien par Élisabeth Tangen et Alexis Fouillet . Varg Veum, ancien salarié à l... » Read more...
GALLIMARD
|
March 2005
|
Upon order :
2 to 4 weeks
|
|
|
|
|
|
$16.95
L'institut de recherches
Une enquête d'Inga-Lisa Östergren. Traduit du suédois par Philippe Bouquet . Un corps retrouvé au large des côtes suédoises par des pêcheurs et qui a... » Read more...
GALLIMARD
|
February 2005
|
Upon order :
2 to 4 weeks
|
|
|
|
|

|
$36.95
Pourquoi l'inspecteur Erlendur use-t-il sa mauvaise humeur à rechercher l'assassin d'un vieil homme dans l'ordinateur duquel on découvre des photos pornographiques immondes et, coincée sous un tiro... » Read more...
METAILIE
|
March 2005
|
Upon order :
2 to 4 weeks
|
|
|
|
|

|
$18.95
«Nous avons Roar. Tu sais où tu peux le trouver. Si tu préviens les flics, on le tue.» Varg Veum, ancien salarié à la protection de l'enfance du port de Bergen, devenu détective privé par défau... » Read more...
GALLIMARD
|
August 2004
|
In stock :
Usually ships in 48 hours.
|
|
|
|
|

|
$17.95
Varg Veum, détective privé de Bergen en Norvège, tente d'oublier son divorce et refuse une mission concernant la filature d'une femme soupçonnée d'adultère par son mari, l'avocat W. Moberg. Quand u... » Read more...
GALLIMARD
|
July 2004
|
Upon order :
2 to 4 weeks
|
|
|
|
|

|
$39.95
Teddy, politologue danois en visite en Europe de l'Est, rencontre Maria qui prétend être sa demi-soeur. De retour à Copenhague, il apprend qu'un homme occupant la chambre d'hôtel qu'il vient de qui... » Read more...
GAIA
|
June 2004
|
In stock :
Usually ships in 3 to 5 days.
|
|
|
|
|

|
$42.95
Avec son sens aigu du dialogue, une intrigue très efficace et un fond de noirceur désespérée qui n'est pas sans rappeler les premiers livres de James Ellroy, on doit tenir Ake Edwardson pour ... » Read more...
LATTES
|
October 2003
|
Upon order :
Usually ships in 2 to 4 weeks.
|
|
|
|
|

|
$35.95
Quand un ambassadeur norvégien est retrouvé dans un motel thaïlandais aux habitudes peu équivoques, un somptueux couteau planté dans le dos, Ça a tendance à faire désordre. Et à Oslo, les sommités ... » Read more...
GAIA
|
May 2004
|
Upon order :
2 to 4 weeks
|
|
|
|
|

|
$41.95

L'inspecteur Wallander, qui espérait un automne calme au retour de ses vacances, se retrouve face à une série de meurtres à donner froid dans le dos. Trois hommes âgés, un ornithologue et poète, un... » Read more...
SEUIL
|
April 2000
|
Upon order :
2 to 4 weeks
|
|
|
|
|

|
$34.95
Plage de Scanie. Il contient les corps de deux hommes exécutés d'une balle dans le cœur. L'origine du canot est vite établie : de fabrication yougoslave à l'usage des Soviétiques et de leurs pays s... » Read more...
SEUIL
|
May 2003
|
Out of stock :
Unavailable
|
|
|
|
|

|
$28.95
Embûches, menaces, identités usurpées et cadavres semblent fleurir sur la route du détective Varg Veum, qui préférerait la compagnie plus aimable de sa fidèle bouteille d'aquavit.
GAIA
|
January 2002
|
Upon order :
2 to 4 weeks
|
|
|
|
|

|
$27.95
Il était difficile de s'y habituer. La femme de vingt-quatre ans qui se trouvait devant elle à fixer le sol était la quarante-deuxième victime de viol à qui l'inspectrice Hanne Wilhelmsen était con... » Read more...
ODIN
|
May 2004
|
Importation :
Usually ships in 2 to 12 weeks
|
|
|
|
|

|
$29.95
Un petit criminel toxicomane est trouvé abattu, le visage atrocement défiguré, au bord de la rivière Aker à Oslo un vendredi soir. Cela n'éveille pas beaucoup l'attention. Mais quand l'avocat de la... » Read more...
ODIN
|
May 2004
|
Importation :
Usually ships in 2 to 12 weeks
|
|
|
|
|

|
$43.50
ODIN
|
May 2004
|
Importation :
Usually ships in 2 to 12 weeks
|
|
|
|
|

|
$29.95
- Tu es triste à cause du monsieur mort, maman ? Oui, répondit-elle tout simplement. Je suis triste à cause du monsieur mort. Mais on ne parlera plus jamais de lui maintenant. Tu m'entends Emma ? P... » Read more...
ODIN
|
May 2004
|
Importation :
Usually ships in 2 to 12 weeks
|
|
|
|
|

|
$105.95
Le descendant d'un prédicateur manipulateur des foules, catastrophé d'avoir perdu le don de soigner, entreprend de tuer pour bénéficier à nouveau de l'aide divine. Les nouvelles aventures d'Erica F... » Read more...
A VUE D'OEIL
|
May 2009
|
Importation :
Usually ships in 2 to 12 weeks
|
|
|
|
|

|
$46.95
Tandis que le commissaire Erlendur part en vacances, son équipe continue à résoudre des affaires. Elinborg est chargée d'une affaire de viol, Sigurdur Oli d'une affaire de pédophilie mais aussi d'u... » Read more...
A VUE D'OEIL
|
September 2012
|
Importation :
Usually ships in 2 to 12 weeks
|
|
|
|
|

|
$46.95
Parti en vacances sur les terres de son enfance dans les régions sauvages des fjords de l'Est, le commissaire Erlendur est hanté par le passé. Il se souvient de tout ce qui s'est déroulé de tragiqu... » Read more...
A VUE D'OEIL
|
April 2013
|
Importation :
Usually ships in 2 to 12 weeks
|
|
|
|
|

|
$88.95

Une nouvelle enquête d'Erica Falck, héroïne de La sirène. Elle doit maintenant s'occuper de ses bébés jumeaux, mène une enquête sur l'île de Gräskar et soutient sa soeur Anne, victime d'un terrible... » Read more...
A VUE D'OEIL
|
July 2013
|
Importation :
Usually ships in 2 to 12 weeks
|
|
|
|
|
|
|
1449 item(s) in your cart.
Renaud-Bray will pay
the shipping costs *
|